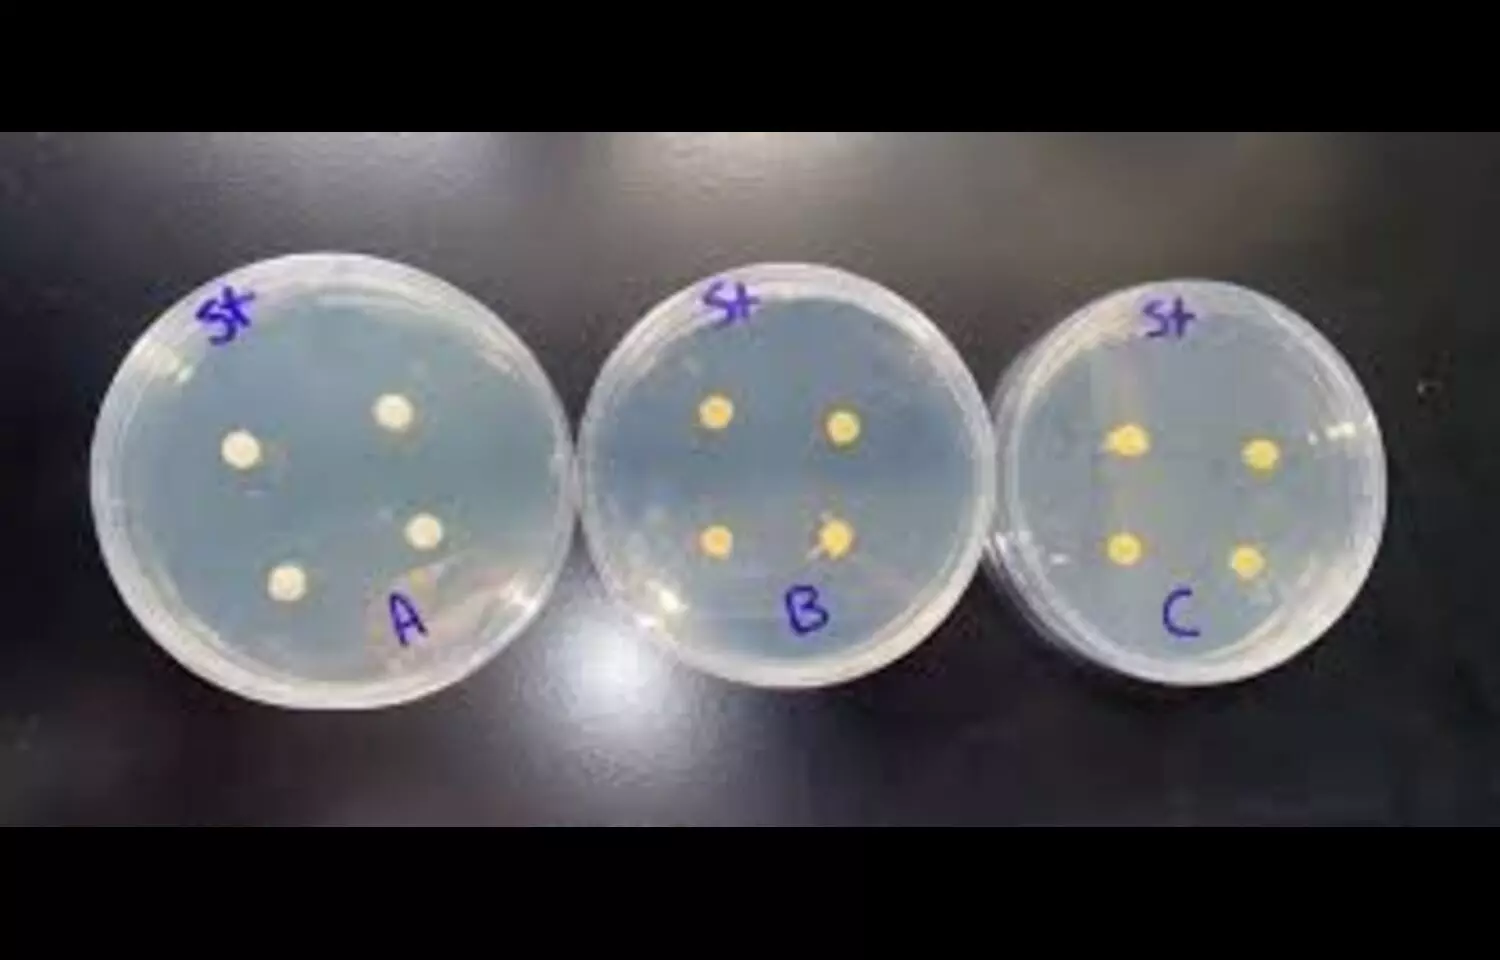

- Home
- Medical news & Guidelines
- Anesthesiology
- Cardiology and CTVS
- Critical Care
- Dentistry
- Dermatology
- Diabetes and Endocrinology
- ENT
- Gastroenterology
- Medicine
- Nephrology
- Neurology
- Obstretics-Gynaecology
- Oncology
- Ophthalmology
- Orthopaedics
- Pediatrics-Neonatology
- Psychiatry
- Pulmonology
- Radiology
- Surgery
- Urology
- Laboratory Medicine
- Diet
- Nursing
- Paramedical
- Physiotherapy
- Health news
- Fact Check
- Bone Health Fact Check
- Brain Health Fact Check
- Cancer Related Fact Check
- Child Care Fact Check
- Dental and oral health fact check
- Diabetes and metabolic health fact check
- Diet and Nutrition Fact Check
- Eye and ENT Care Fact Check
- Fitness fact check
- Gut health fact check
- Heart health fact check
- Kidney health fact check
- Medical education fact check
- Men's health fact check
- Respiratory fact check
- Skin and hair care fact check
- Vaccine and Immunization fact check
- Women's health fact check
- AYUSH
- State News
- Andaman and Nicobar Islands
- Andhra Pradesh
- Arunachal Pradesh
- Assam
- Bihar
- Chandigarh
- Chattisgarh
- Dadra and Nagar Haveli
- Daman and Diu
- Delhi
- Goa
- Gujarat
- Haryana
- Himachal Pradesh
- Jammu & Kashmir
- Jharkhand
- Karnataka
- Kerala
- Ladakh
- Lakshadweep
- Madhya Pradesh
- Maharashtra
- Manipur
- Meghalaya
- Mizoram
- Nagaland
- Odisha
- Puducherry
- Punjab
- Rajasthan
- Sikkim
- Tamil Nadu
- Telangana
- Tripura
- Uttar Pradesh
- Uttrakhand
- West Bengal
- Medical Education
- Industry
Antibiotic-Modified glass ionomer cement : Antibacterial Efficacy and Strength
Researchers have conducted a new study highlighting the performance of antibiotic-modified glass ionomer cement compared to standard formulations. They found that among the experimental variations, the antibiotic-modified glass ionomer cement showed the highest antibacterial efficacy. They further found that within the experimental groups, this modified version also demonstrated superior compressive strength. While the modified glass ionomer cement performed well, the standard control group (unmodified glass ionomer cement) still retained the highest overall compressive strength.
The incorporation of chlorhexidine dihydrochloride and chlorhexidine diacetate into glass ionomer cements enhances antimicrobial effects without significantly compromising physical properties. Takahashi et al. used high-performance liquid chromatography to show significant chlorhexidine release from experimental glass ionomer cement formulations, concluding that 1% chlorhexidine diacetate was optimal for FUJI IX glass ionomer cement. Based on Emilson et al., this study selected 2% chlorhexidine, known for its antibacterial activity against caries-associated bacteria, incorporated as a powder into FUJI IX glass ionomer cement. Higher concentrations of chlorhexidine compromised restorative material properties, justifying the selection of 2% chlorhexidine. This study found that 2% chlorhexidine increased antibacterial properties against Streptococcus mutans compared to conventional glass ionomer cement (mean inhibition zone: 4.90 ± 0.22 millimeters versus 2.75 ± 0.36 millimeters, p < 0.01), but its efficacy was lower than other agents tested. Additionally, 2% chlorhexidine caused a greater reduction in compressive strength (mean: 101.18 ± 1.62 megapascals) compared to other agents, with a mean difference of 64.76 megapascals from the control.
Cationic disinfectants, such as cetrimide, cetylpyridinium chloride, and benzalkonium chloride, have been studied for their antibacterial effects. This study used 1% cetrimide in FUJI IX glass ionomer cement, as Deepalakshmi et al. found this concentration optimal for antibacterial effects without compromising physical properties. The results confirmed significant antimicrobial activity (mean inhibition zone: 6.05 ± 0.21 millimeters, p < 0.01) and maintained physical properties (mean compressive strength: 141.49 ± 1.35 megapascals), with cetrimide showing higher antibacterial efficacy and compressive strength than 2% chlorhexidine and 2.5% triclosan, but lower than antibiotics (1.5%). Sato et al. found the ternary antibiotic combination effective in sterilizing carious lesions, necrotic pulps, and infected root dentin in deciduous teeth, both in vitro and in vivo. In this study, the antibiotic mixture (1.5%) demonstrated the highest antibacterial efficacy (mean inhibition zone: 10.70 ± 0.43 millimeters, p < 0.01) and the least reduction in compressive strength (mean: 149.29 ± 2.56 megapascals) among experimental groups. Triclosan, a broad-spectrum antimicrobial agent, was incorporated into FUJI IX glass ionomer cement at a 2.5% concentration, as investigated by Sainulabdeen et al.
This study found that triclosan significantly enhanced antibacterial efficacy against Streptococcus mutans (mean inhibition zone: 5.27 ± 0.31 millimeters, p < 0.01) compared to the control group, though its efficacy was lower than cetrimide and antibiotics but higher than chlorhexidine. The incorporation of triclosan, however, resulted in a notable reduction in compressive strength (mean: 130.98 ± 1.44 megapascals), with a mean difference of 34.96 megapascals from the control, placing it between cetrimide and chlorhexidine in terms of physical property impact. Somani et al. reported that triclosan-incorporated glass ionomer cement exhibited adequate antibacterial properties but increased microleakage, suggesting potential limitations in clinical sealing performance. The 2.5% concentration used in this study aligns with prior research indicating effective antibacterial activity, but the trade-off in compressive strength highlights the need for careful consideration of triclosan concentration to balance antimicrobial benefits and mechanical integrity.
All experimental glass ionomer cements demonstrated antibacterial efficacy, but the incorporation of antibacterial agents significantly reduced compressive strength. Experimental glass ionomer cement containing antibiotics (1.5% metronidazole, ciprofloxacin, and minocycline) exhibited greater antibacterial efficacy and compressive strength compared to other experimental groups. The highest compressive strength was observed in the control group (FUJI IX glass ionomer cement).
Reference:
Ponangi, Kalyana, et al. Antibacterial Efficacy and Compressive Strength of Modified Glass Ionomer Cements. Bioinformation, vol. 21, no. 9, 2025, pp. 3135–3139.
Dr. Shravani Dali has completed her BDS from Pravara institute of medical sciences, loni. Following which she extensively worked in the healthcare sector for 2+ years. She has been actively involved in writing blogs in field of health and wellness. Currently she is pursuing her Masters of public health-health administration from Tata institute of social sciences. She can be contacted at editorial@medicaldialogues.in.
Dr Kamal Kant Kohli-MBBS, DTCD- a chest specialist with more than 30 years of practice and a flair for writing clinical articles, Dr Kamal Kant Kohli joined Medical Dialogues as a Chief Editor of Medical News. Besides writing articles, as an editor, he proofreads and verifies all the medical content published on Medical Dialogues including those coming from journals, studies,medical conferences,guidelines etc. Email: drkohli@medicaldialogues.in. Contact no. 011-43720751


